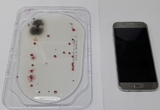

-

<문화TV> 이동훈 한국가요작가협회장 “한국가요계를 그리다”
- 2018-08-31 20:05
- 금교영 기자
-

서울시, 청계광장서 지하도상가 프리마켓 ‘두더지마켓’ 연다
- 2018-08-31 16:55
- 금교영 기자
-

담양군, 메타프로방스 집행정지 취소… 정상화·조기 완공 ‘박차’
- 2018-08-31 16:16
- 금교영 기자
-

경기도, 남한산성 수호천사 체험 프로그램 운영
- 2018-08-31 14:34
- 금교영 기자
-

국내 최초 운전자 없는 자율주행차 ‘제로셔틀’ 다음달 4일부터 판교서 시범운행
- 2018-08-30 17:54
- 금교영 기자
-
전남도, 집중호우 대처상황 점검… 2차 피해 방지 등 선제적 현장 관리 나서
- 2018-08-30 17:13
- 금교영 기자
-

경북 산림관광 정보를 한눈에 본다 ‘휴대용 산림관광지도’ 발간
- 2018-08-30 17:07
- 금교영 기자
-

“반려견 모두 모여라” 속초시, 다음달 9일 반려견 문화축제 개최
- 2018-08-30 16:35
- 금교영 기자
-

경기도, 목공·가죽 등 생활밀착형 메이커문화 확산 시동
- 2018-08-30 14:14
- 금교영 기자
-

대전시 “청소년 휴대전화, 미생물 오염도·항생제 내성 조사”
- 2018-08-30 11:09
- 금교영 기자
-

[방방곡곡 레이더] 전남도-담양군, 스낵과자류 등 기업 8곳 유치… 381억 규모 투자협약…
- 2018-08-29 17:44
- 금교영 기자
-

경북도, 공무원 재택근무 전격 시행… 아이 키우기 좋은 환경 조성한다
- 2018-08-29 16:55
- 금교영 기자
-

어둠 속 반딧불 향연 펼쳐진다… 순천시, 미드리 반딧불 축제 다음달 2일 개막
- 2018-08-29 16:29
- 금교영 기자
-

“부산에서 즐기는 진짜 세계여행” 내달 7~10일 부산국제관광전 개최
- 2018-08-29 15:39
- 금교영 기자
-

천안시-남서울대, 드론 기술발전 및 인프라 구축 MOU
- 2018-08-29 15:20
- 금교영 기자
-

경기도, 기초수급자 복지급여 2억4500만원 떼먹은 친인척 등 16명 적발
- 2018-08-29 14:10
- 금교영 기자
-

청주시, 횡단보도 LED 조명 설치 확대 “야간 교통사고 예방”
- 2018-08-29 13:39
- 금교영 기자
-

“숲속 좋은 향기 무료로 나눠드려요” 김해시, 목재문화체험장 ‘숲 체험실’ 개장
- 2018-08-29 12:03
- 금교영 기자
-

충남도서관, 9월 ‘독서의 달’ 문화행사 풍성
- 2018-08-29 11:37
- 금교영 기자
-

양승조 충남지사, “부여를 세계적인 역사·문화·관광 도시로”
- 2018-08-28 17:54
- 금교영 기자
-

“무등록 건설업체 시공 피해 막아요”… 대전시, 피해예방 홍보포스터 배포
- 2018-08-28 16:30
- 금교영 기자
-

경기도, 여성·청소년 불법촬영 및 유포 등 피의자 31명 검거
- 2018-08-28 16:21
- 금교영 기자
-
강원도, 청소년 평화현장 체험 및 DMZ 견학 실시
- 2018-08-28 15:56
- 금교영 기자
-

경인제약, 신기깔창 이제 다이소에서 사세요
- 2018-08-28 14:44
- 금교영 기자
- 정치尹대통령, 연말 선물로 수입농산물 보내 '논란'
- 경제주스부터 아이스크림까지...숙취해소제 시장 커진다
- 사회주먹이 '펜' 쥐니 더 무섭네...조폭출신 기자 횡포로 제천시 '발칵'
- 국제인도네시아 회사가 뉴진스 모델로 '한국라면' 출시…왜?
- 문화연예"동백꽃보고 쭈꾸미도 먹고" 오는 22일 '동백꽃.쭈꾸미 축제'
- 오피니언<송결스페셜칼럼> KR팝 발전협의회 '문화페스티벌 쇼'
- 라이프 스타일'간헐적 절식'이 소식보다 지방간 감소 효과 커
- 여행레저'물억새 장관' 충주 앙성 비내섬 축제 21일 개막
- 영상김교흥 후보 "8년 동안 묵묵히 서구 주민들과 함께...일할 기회 달라"
- 포토[포토] 불경기라는데...국회 의원회관에 가득 쌓인 설 선물세트
(본사) 충북 충주시 신니면 신덕로 437 | TEL : 043-854-5952 ㅣ FAX : 043-844-5952 (서울본부) 서울시 영등포구 양평동4가 280-8(선유로 274) 3층 | TEL : 02-2671-0203 | FAX : 02-2671-0244 (충남본부) 충남 천안시 동남구 천안대로 553, 2층 (구성동 426-3) l TEL: 041-565-7081 l FAX 041-565-7083 등록번호 : 충북, 아00250 | 등록일 : 2021년 8월 13일 | 발행인·편집인 : 황재연 Copyright @문화투데이 Corp. All rights reserved.